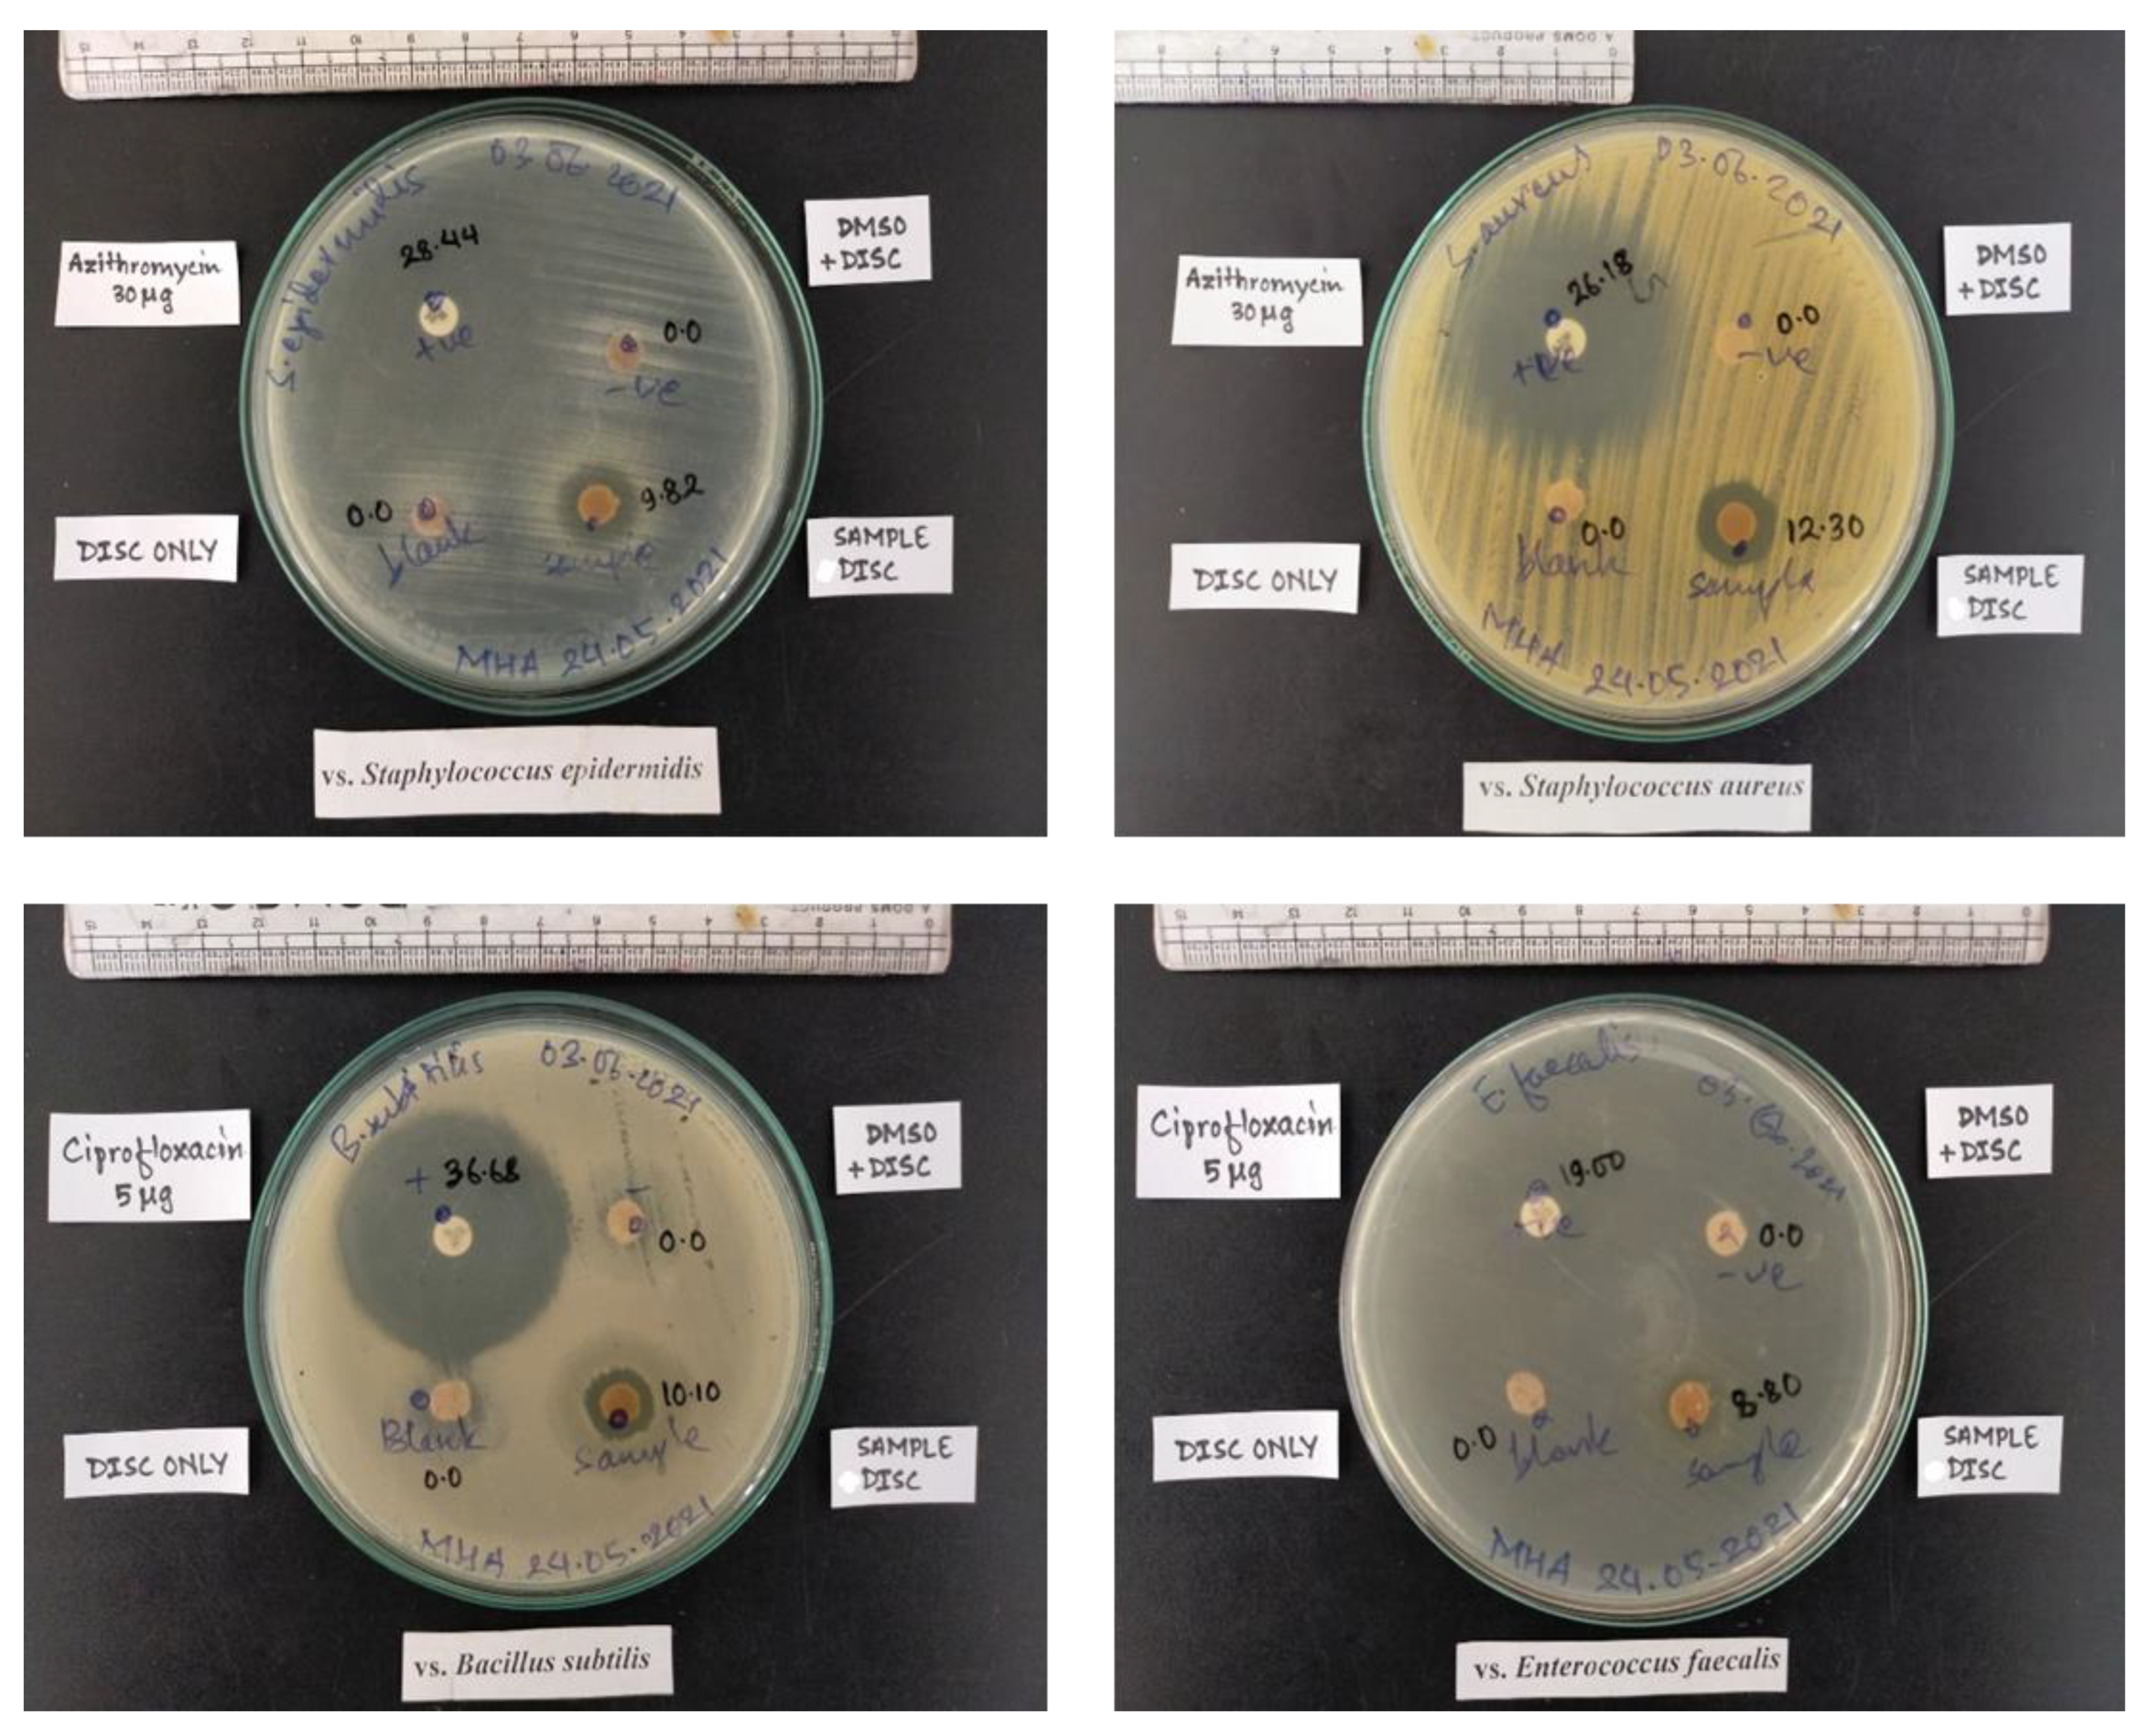
Membranes 12 01089 g007 Membranes 12 01089 g007

The Encapsulation of Bioactive Plant Extracts into the Cellulose Microfiber Isolated from G. optiva Species for Biomedical Applications
Abstract
1. Introduction
2. Methods and Materials
2.1. Extraction of Cellulose Microfibers
2.2. Extraction of C. roseus Roots
2.3. Preparation of the Plant Extract Incorporated Membrane (CMF-E)
2.4. Measurement of Apparent Densities
2.5. Chemical Composition Measurement of GOFs Fibers
2.6. Physicochemical Characterization
2.7. Antibacterial Activity
2.8. Evaluation of Plant Extract Encapsulation in CMF Membrane
2.9. Water Uptake of CMF-E Membrane
2.10. Active Principle Ingredients (API) (Extract) Release from CMF-E
3. Results and Discussion
3.1. Physiochemical Characterization of G. Optiva Fibers
3.2. X-ray Diffraction (XRD) Analysis
3.3. Fourier Transform Infrared (FTIR) Spectroscopy Analysis
3.4. Microscopic Characterization
3.5. Water Uptake Efficiency
3.6. Antimicrobial Screening of Different Membranes
4. Conclusions
Author Contributions
Funding
Institutional Review Board Statement
Informed Consent Statement
Data Availability Statement
Conflicts of Interest
References
- Available online: https://apps.worldagroforestry.org/treedb/AFTPDFS/Grewia_optiva.PDF (accessed on 12 July 2022).
- Thomas, S.; Paul, S.; Pothan, L.; Deepa, B. Natural fibres: Structure, properties and applications. In Cellulose fibers: Bio-and Nano-Polymer Composites; Springer: Berlin/Heidelberg, Germany, 2011; pp. 3–42. [Google Scholar]
- John, M.; Anandjiwala, R. Recent developments in chemical modification and characterization of natural fiber-reinforced composites. Polym. Compos. 2008, 29, 187–207. [Google Scholar] [CrossRef]
- Chaudary, A.; Chudhary, T.; Patoary, M.K.; Zhang, M.; Jiang, S.; Li, M.; Liu, L. Nanoscale cellulose and nanocellulose-based aerogels. In Advanced Materials for Sustainable Environmental Remediation; Elsevier: Amsterdam, The Netherlands, 2022; pp. 229–260. [Google Scholar]
- Li, Q.; Liu, Y.; Wang, Y.; Chen, Y.; Guo, X.; Wu, Z.; Zhong, B. Review of the application of biomass-derived porous carbon in lithium-sulfur batteries. Ionics 2020, 26, 4765–4781. [Google Scholar] [CrossRef]
- Abdul Khalil, H.P.S.; Bhat, A.H.; Ireana Yusra, A.F. Green composites from sustainable cellulose nanofibrils: A review. Carbohydr. Polym. 2012, 87, 963–979. [Google Scholar] [CrossRef]
- Trache, D.; Tarchoun, A.F.; Derradji, M.; Hamidon, T.S.; Masruchin, N.; Brosse, N.; Hussin, M.H. Nanocellulose: From Fundamentals to Advanced Applications. Front. Chem. 2020, 8, 392. [Google Scholar] [CrossRef] [PubMed]
- Chu, Y.; Sun, Y.; Wu, W.; Xiao, H. Dispersion Properties of Nanocellulose: A Review. Carbohydr. Polym. 2020, 250, 116892. [Google Scholar] [CrossRef]
- Oun, A.A.; Shankar, S.; Rhim, J.-W. Multifunctional nanocellulose/metal and metal oxide nanoparticle hybrid nanomaterials. Crit. Rev. Food Sci. Nutr. 2020, 60, 435–460. [Google Scholar] [CrossRef]
- Zinge, C.; Kandasubramanian, B. Nanocellulose based Biodegradable Polymers. Eur. Polym. J. 2020, 133, 109758. [Google Scholar] [CrossRef]
- Lim, Y.Y.; Miskon, A.; Zaidi, A.M.A. Structural Strength Analyses for Low Brass Filler Biomaterial with Anti-Trauma Effects in Articular Cartilage Scaffold Design. Materials 2022, 15, 4446. [Google Scholar] [CrossRef]
- Lim, Y.Y.; Miskon, A.; Zaidi, A.M.A.; Megat Ahmad, M.M.H.; Abu Bakar, M. Structural Characterization Analyses of Low Brass Filler Biomaterial for Hard Tissue Implanted Scaffold Applications. Materials 2022, 15, 1421. [Google Scholar] [CrossRef]
- Lim, Y.Y.; Miskon, A.; Zaidi, A.M.A.; Megat Ahmad, M.M.H.; Abu Bakar, M. Numerical Simulation Study on Relationship between the Fracture Mechanisms and Residual Membrane Stresses of Metallic Material. J. Funct. Biomater. 2022, 13, 20. [Google Scholar] [CrossRef]
- Nejat, N.; Valdiani, A.; Cahill, D.; Tan, Y.-H.; Maziah, M.; Abiri, R. Ornamental Exterior versus Therapeutic Interior of Madagascar Periwinkle (Catharanthus roseus): The Two Faces of a Versatile Herb. Sci. World J. 2015, 2015, 982412. [Google Scholar] [CrossRef] [PubMed]
- El-Sayed, M.; Verpoorte, R. Catharanthus terpenoid indole alkaloids: Biosynthesis and regulation. Phytochem. Rev. 2007, 6, 277–305. [Google Scholar] [CrossRef]
- Pham, H.N.T.; Sakoff, J.A.; Vuong, Q.V.; Bowyer, M.C.; Scarlett, C.J. Phytochemical, antioxidant, anti-proliferative and antimicrobial properties of Catharanthus roseus root extract, saponin-enriched and aqueous fractions. Mol. Biol. Rep. 2019, 46, 3265–3273. [Google Scholar] [CrossRef] [PubMed]
- Nayak, B.; Pinto Pereira, L.M. Catharanthus roseus flower extract has wound-healing activity in Sprague Dawley rats. BMC Complementary Altern. Med. 2006, 6, 1–6. [Google Scholar] [CrossRef]
- Nayak, B.; Anderson, M.; Pereira, L.P. Evaluation of wound-healing potential of Catharanthus roseus leaf extract in rats. Fitoterapia 2007, 78, 540–544. [Google Scholar] [CrossRef]
- Hariani, P.; Riyanti, F.; Asmara, R. Extraction of Cellulose from Kepok Banana Peel (Musa parasidiaca L.) for Adsorption Procion Dye. Molekul 2016, 11, 135. [Google Scholar] [CrossRef]
- Morán, J.; Alvarez, V.; Cyras, V.; Vázquez, A. Extraction of cellulose and preparation of nanocellulose from sisal fibers. Cellulose 2008, 15, 149–159. [Google Scholar] [CrossRef]
- Jennings, D.; Weispfennig, K. Experimental solubility data of various n-alkane waxes: Effects of alkane chain length, alkane odd versus even carbon number structures, and solvent chemistry on solubility. Fluid Phase Equilibria 2005, 227, 27–35. [Google Scholar] [CrossRef]
- Jeffries, T.W. Biodegradation of lignin-carbohydrate complexes. Biodegradation 1990, 1, 163–176. [Google Scholar] [CrossRef]
- Lee, H.V.; Hamid, S.B.A.; Zain, S.K. Conversion of Lignocellulosic Biomass to Nanocellulose: Structure and Chemical Process. Sci. World J. 2014, 2014, 631013. [Google Scholar] [CrossRef]
- Cielecka, I.; Szustak, M.; Kalinowska, H.; Gendaszewska-Darmach, E.; Ryngajłło, M.; Maniukiewicz, W.; Bielecki, S. Glycerol-plasticized bacterial nanocellulose-based composites with enhanced flexibility and liquid sorption capacity. Cellulose 2019, 26, 5409–5426. [Google Scholar] [CrossRef]
- Durand, H.; Jaouen, P.; Faure, E.; Sillard, C.; Belgacem, N.; Zeno, E.; Bras, J. Pure cellulose nanofibrils membranes loaded with ciprofloxacin for drug release and antibacterial activity. Cellulose 2020, 27, 7037–7052. [Google Scholar] [CrossRef]
- Inglesby, M.; Gray, G.; Wood, D.; Gregorski, K.; Robertson, R.; Sabellano, G. Surface characterization of untreated and solvent-extracted rice straw. Colloids Surfaces. B Biointerfaces 2005, 43, 83–94. [Google Scholar] [CrossRef]
- Reddy, K.O.; Uma Maheswari, C.; Muzenda, E.; Shukla, M.; Rajulu, A.V. Extraction and Characterization of Cellulose from Pretreated Ficus (Peepal Tree) Leaf Fibers. J. Nat. Fibers 2016, 13, 54–64. [Google Scholar] [CrossRef]
- Chand, N.; Fahim, M. 4–Jute-Reinforced Polymer Composites. In Tribology of Natural Fiber Polymer Composites, 2nd ed.; Chand, N., Fahim, M., Eds.; Woodhead Publishing: Cambridge, UK, 2021; pp. 111–130. [Google Scholar]
- Tanpichai, S.; Sampson, W.W.; Eichhorn, S.J. Stress-transfer in microfibrillated cellulose reinforced poly(lactic acid) composites using Raman spectroscopy. Compos. Part A Appl. Sci. Manuf. 2012, 43, 1145–1152. [Google Scholar] [CrossRef]
- Zhang, C.; Uchikoshi, T.; Ichinose, I.; Liu, L. Surface Modification on Cellulose Nanofibers by TiO2 Coating for Achieving High Capture Efficiency of Nanoparticles. Coatings 2019, 9, 139. [Google Scholar] [CrossRef]
- Mahardika, M.; Abral, H.; Kasim, A.; Arief, S.; Asrofi, M. Production of Nanocellulose from Pineapple Leaf Fibers via High-Shear Homogenization and Ultrasonication. Fibers 2018, 6, 28. [Google Scholar] [CrossRef]
- Kusmono, K.; Listyanda, F.; Wildan, M.; Ilman, M. Preparation and characterization of cellulose nanocrystal extracted from ramie fibers by sulfuric acid hydrolysis. Heliyon 2020, 6, e05486. [Google Scholar] [CrossRef]
- Xu, X.; Liu, F.; Jiang, L.; Zhu, J.Y.; Haagenson, D.; Wiesenborn, D.P. Cellulose Nanocrystals vs. Cellulose Nanofibrils: A Comparative Study on Their Microstructures and Effects as Polymer Reinforcing Agents. ACS Appl. Mater. Interfaces 2013, 5, 2999–3009. [Google Scholar] [CrossRef]
- Hospodarova, V.; Singovszka, E.; Stevulova, N. Characterization of cellulosic fibers by FTIR spectroscopy for their further implementation to building materials. Am. J. Anal. Chem. 2018, 9, 303–310. [Google Scholar] [CrossRef]
- Poletto, M.; Pistor, V.; Zeni, M.; Zattera, A. Crystalline properties and decomposition kinetics of cellulose fibers in wood pulp obtained by two pulping processes. Polym. Degrad. Stab.-Polym. Degrad. Stabil. 2011, 96, 679–685. [Google Scholar] [CrossRef]
- El-Sakhawy, M.; Kamel, S.; Salama, A.; Sarhan, H.-A. Preparation and infrared study of cellulose based amphiphilic materials. Cellul. Chem. Technol. 2018, 52, 193–200. [Google Scholar]
- Lani, N.S.; Ngadi, N.; Johari, A.; Jusoh, M. Isolation, characterization, and application of nanocellulose from oil palm empty fruit bunch fiber as nanocomposites. J. Nanomater. 2014, 2014, 13. [Google Scholar] [CrossRef]
- Wang, J.; Wang, Q.; Wu, Y.; Bai, F.; Wang, H.; Si, S.; Lu, Y.; Li, X.; Wang, S. Preparation of Cellulose Nanofibers from Bagasse by Phosphoric Acid and Hydrogen Peroxide Enables Fibrillation via a Swelling, Hydrolysis, and Oxidation Cooperative Mechanism. Nanomaterials 2020, 10, 2227. [Google Scholar] [CrossRef]
- Available online: https://pubs.acs.org/doi/abs/10.1021/acsami.5b04682 (accessed on 12 April 2022).
- Available online: https://www.scirp.org/journal/paperinformation.aspx?paperid=112956 (accessed on 15 August 2022).
- Joshi, M.K.; Tiwari, A.P.; Pant, H.R.; Shrestha, B.K.; Kim, H.J.; Park, C.H.; Kim, C.S. In Situ Generation of Cellulose Nanocrystals in Polycaprolactone Nanofibers: Effects on Crystallinity, Mechanical Strength, Biocompatibility, and Biomimetic Mineralization. ACS Appl. Mater. Interfaces 2015, 7, 19672–19683. [Google Scholar] [CrossRef]
- Rostamitabar, M.; Ghahramani, A.; Seide, G.; Jockenhoevel, S.; Ghazanfari, S. Drug loaded cellulose–chitosan aerogel microfibers for wound dressing applications. Cellulose 2022, 29, s6261–s6281. [Google Scholar] [CrossRef]
- Available online: https://sci-hub.se/10.1007/s10570-014-0368-2 (accessed on 8 July 2022).
- Haider, A.; Kwak, S.; Gupta, K.C.; Kang, I.-K. Antibacterial Activity and Cytocompatibility of PLGA/CuO Hybrid Nanofiber Scaffolds Prepared by Electrospinning. J. Nanomater. 2015, 2015, 832762. [Google Scholar] [CrossRef]
- Jenkins, T.; Knepper, B.; Moore, S.J.; Saveli, C.; Pawlowski, S.; Perlman, D.; McCollister, B.; Burman, W. Comparison of the Microbiology and Antibiotic Treatment among Diabetic and Nondiabetic Patients Hospitalized for Cellulitis or Cutaneous Abscess. J. Hosp. Med. 2014, 9, 788–794. [Google Scholar] [CrossRef]
- Bhattarai, T.; Raja, M.Y.A.; Ebong, A.; Bhutta, M.K. On the nano-engineered III-nitride quantum-wells-based deep-UV light emitting diodes for COVID disinfection applications. In Proceedings of the Second iiScience International Conference 2021: Recent Advances in Photonics and Physical Sciences 2021, Faisalabad, Pakistan, 29–30 March 2021; Available online: https://www.spiedigitallibrary.org/conference-proceedings-of-spie/11877/118770A/On-the-nano-engineered-III-nitride-quantum-wells-based-deep/10.1117/12.2600576.short (accessed on 10 September 2022).

| Agroforestry Waste | Cellulose (%) | Hemicellulose (%) | Lignin (%) | Reference |
|---|---|---|---|---|
| Hardwood stem | 40–45 | 24–40 | 18–25 | [26] |
| Softwood stem | 45–50 | 25–30 | 25–35 | [26] |
| Ficus leaves | 38.1 | 30.5 | 23.4 | [27] |
| Jute | 61–71 | 14–20 | 12–13 | [3,28] |
| G. optiva (bark) | ≈63.3 | ≈13.52 | ≈15.13 | Present work |
| Area (cm2) | Weight (g) | Thickness (cm) | Grammage (g/cm2) | Apparent Density (g/cm3) |
|---|---|---|---|---|
| CMF1 | 0.030 | 0.047 | 0.030 | 0.638 |
| CMF2 | 0.058 | 0.053 | 0.026 | 0.486 |
| CMF3 | 0.129 | 0.062 | 0.032 | 0.520 |
| Sample | Peak Position (2θ) in Degrees | d-Spacing (A) d200 | FWHM (Degree) | Crystalline Size L (nm) | Crystallinity Index |
|---|---|---|---|---|---|
| CMF | 22.99 | 3.86 | 3.17 | 2.53 | 30.04 |
| CMF-E | 23.34 | 3.80 | 3.22 | 2.49 | 27.99 |
Publisher’s Note: MDPI stays neutral with regard to jurisdictional claims in published maps and institutional affiliations. |
© 2022 by the authors. Licensee MDPI, Basel, Switzerland. This article is an open access article distributed under the terms and conditions of the Creative Commons Attribution (CC BY) license (https://creativecommons.org/licenses/by/4.0/).
Share and Cite
Panthi, K.P.; Gyawali, A.; Pandeya, S.; Sharma Bhusal, M.L.; Neupane, B.B.; Tiwari, A.P.; Joshi, M.K. The Encapsulation of Bioactive Plant Extracts into the Cellulose Microfiber Isolated from G. optiva Species for Biomedical Applications. Membranes 2022, 12, 1089. https://doi.org/10.3390/membranes12111089
Panthi KP, Gyawali A, Pandeya S, Sharma Bhusal ML, Neupane BB, Tiwari AP, Joshi MK. The Encapsulation of Bioactive Plant Extracts into the Cellulose Microfiber Isolated from G. optiva Species for Biomedical Applications. Membranes. 2022; 12(11):1089. https://doi.org/10.3390/membranes12111089
Chicago/Turabian StylePanthi, Khim Prasad, Aashish Gyawali, Shiva Pandeya, Motee Lal Sharma Bhusal, Bhanu Bhakta Neupane, Arjun Prasad Tiwari, and Mahesh Kumar Joshi. 2022. "The Encapsulation of Bioactive Plant Extracts into the Cellulose Microfiber Isolated from G. optiva Species for Biomedical Applications" Membranes 12, no. 11: 1089. https://doi.org/10.3390/membranes12111089
APA StylePanthi, K. P., Gyawali, A., Pandeya, S., Sharma Bhusal, M. L., Neupane, B. B., Tiwari, A. P., & Joshi, M. K. (2022). The Encapsulation of Bioactive Plant Extracts into the Cellulose Microfiber Isolated from G. optiva Species for Biomedical Applications. Membranes, 12(11), 1089. https://doi.org/10.3390/membranes12111089

